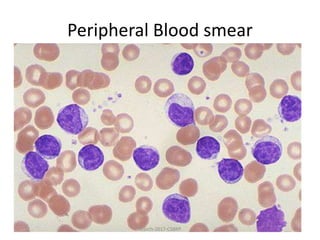
Peripheral Blood smear
March-2017-CSBRP

This document summarizes several case studies involving lymphomas:
Case 1 involves a 52-year-old female with enlarged lymph nodes and lung lesions. Biopsies of the lymph nodes and lung lesion were performed.
Case 2 involves a 40-year-old female with gastric pain and abnormalities found during endoscopy. A gastric biopsy was performed.
Case 3 involves a 5-year-old girl with a rapidly growing jaw swelling. Imaging and biopsies were performed to investigate.
Case 4 involves a 70-year-old male being evaluated for weakness found to have lymphadenopathy. Testing of lymph nodes and bone marrow was done.
The document discusses findings and next steps for each case